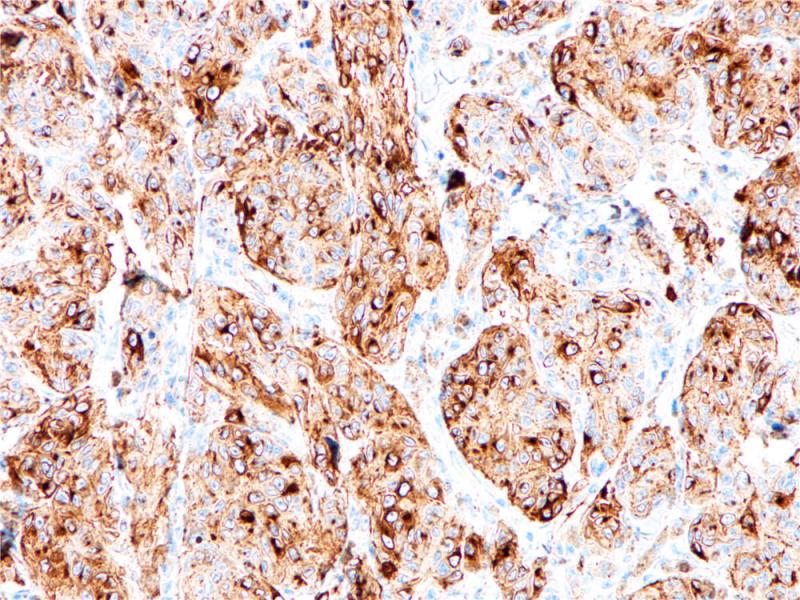
黑色素瘤 PMEL17 (BP6031) 染色

产品中心

黑色素瘤 PMEL17 (BP6031) 染色
黑色素瘤 PMEL17 (BP6031) 染色
PMEL 17 重组兔单克隆抗体
PMEL17是黑色素小体专一抗原,也称作HMB45或GP100。PMEL17在黑色素细胞从I阶到II阶发育成熟的过程中起到重要作用,其从I阶到II阶的转变是囊泡的伸长,内部形态为清晰的纤维状结构。PMEL17分布于未成熟以及活化的黑色素细胞(如炎症,增生的血管或潜在的肿瘤),不存在于成熟和静息的黑色素细胞。PMEL17在黑色素瘤中也有表达。研究表明PMEL17的常规使用可作为灵敏特定的黑色素细胞标记。
Specifications
- 目录号
- BX50026
- 克隆号
- BP6031
- 阳性对照
- 黑色素瘤
- 亚细胞定位
- 细胞质
- 组织类型
- FFPE
- 修复方式
- HIER
- 稀释比
- 1:100-1:200
- 规格
- 100μl/vial, 1ml/vial
- 用途
- RUO
Reference
1.Rothberg BE, et.al, Mod Pathol. 2008 Sep;21(9):1121-9.
2.Wagner SN, et.al, Cancer Immunol Immunother. 1997 Jun;44(4):239-47.


